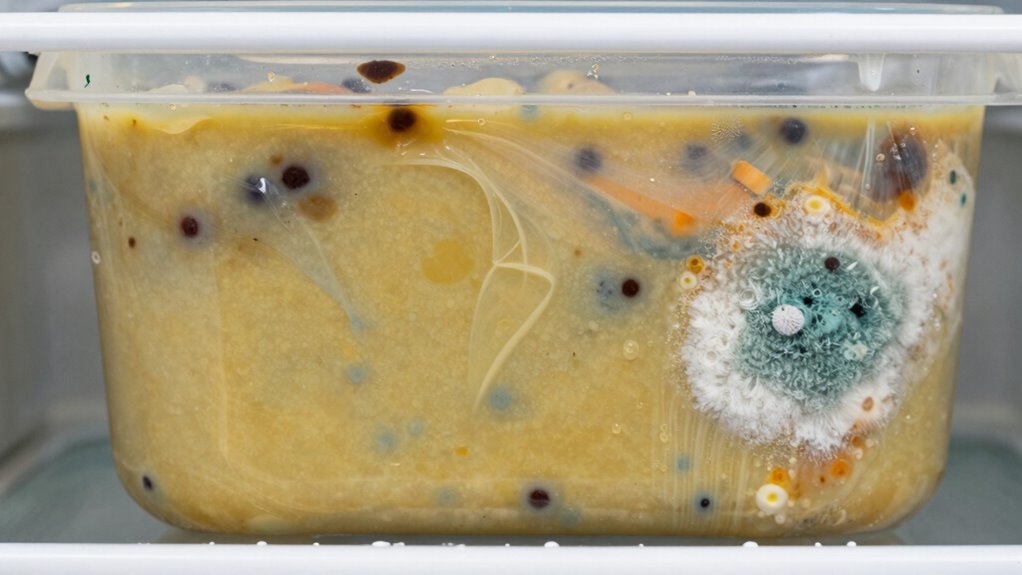
check odors colors appearance
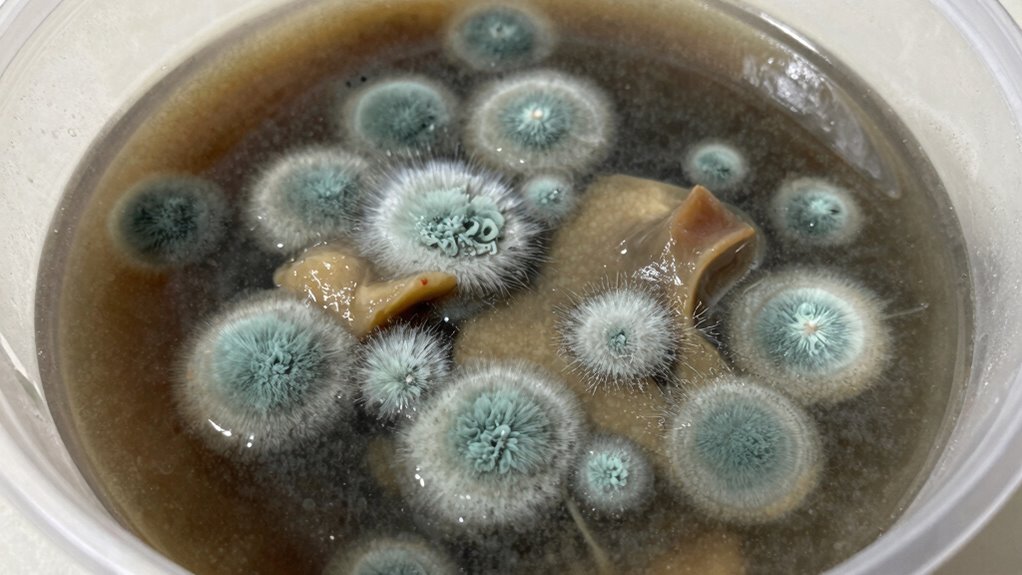
spot mold and spoilage

If leftovers develop a sour or off smell, strange colors, or fuzzy mold, you should toss them immediately to avoid food poisoning. Look for slimy textures, discoloration, or unusual spots, and avoid eating anything that looks or smells suspicious. If reheated leftovers cause stomach upset or symptoms, discard them right away. Proper storage and quick disposal of spoiled items are key—continue exploring for more tips to keep your food safe.
Key Takeaways
- Discard leftovers with foul, sour, or rancid odors indicating spoilage.
- Toss food showing mold, fuzzy spots, or discoloration, especially if fuzzy or fuzzy patches are visible.
- Avoid eating leftovers that have a slimy, mushy, or unusual texture or taste.
- Dispose of any leftovers causing symptoms like nausea or stomach discomfort after consumption.
- Always reheat leftovers to an internal temperature of 165°F (74°C) to ensure safety before eating.

Alpha Grillers Meat Thermometer Digital – Instant Read Food Thermometer for Cooking & Grilling – Professional Kitchen Fathers Day Gift for Dad Men Him Husband
Instant Read Food Thermometer | Our instant read thermometer features a temperature probe and advanced, highly accurate technology…
As an affiliate, we earn on qualifying purchases.
As an affiliate, we earn on qualifying purchases.
How to Recognize Spoiled Leftovers (Odors, Colors, and Appearance)
Knowing how to spot spoiled leftovers is essential to avoid food poisoning. Start with odor detection—trust your nose. If leftovers emit a sour, rancid, or off-putting smell, it’s a clear sign they’ve gone bad. Additionally, air quality considerations can influence how quickly food spoils, so proper storage is vital. Good storage practices can significantly extend the freshness of leftovers. Next, assess the color; fresh leftovers should retain their typical appearance. If you notice any discoloration, such as dullness, greenish tints, or unusual spots, it’s safest to discard them. Also, examine the overall appearance—look for slime, mold, or any strange textures. These visual cues are often the first signs of spoilage. Additionally, understanding the color accuracy of leftovers can help you determine if they are still safe to eat, as faded or dull colors may indicate deterioration. Proper food safety awareness is crucial, as consuming spoiled leftovers can lead to serious health issues. Remember, your senses are your best tools for safety. When in doubt, it’s better to throw leftovers away than risk foodborne illness. Always prioritize caution over convenience to keep yourself healthy.

Bentgo Prep – 20-Piece 1-Compartment Reusable Meal Prep Containers with Lids, PFAS & BPA Free Materials, Durable, Microwave, Freezer, & Dishwasher Safe To Go Food Storage (Mint)
#1 Brand Pick for Meal Prep Containers: Bentgo is the top pick for meal prep containers!* This lightweight,…
As an affiliate, we earn on qualifying purchases.
As an affiliate, we earn on qualifying purchases.
What Texture Changes Indicate Leftover Spoilage

Changes in texture are key indicators that leftovers may have spoiled. You should watch out for texture deterioration, such as a mushy or overly soft consistency that wasn’t present when you stored it. A slimy surface is a strong sign of bacterial growth and spoilage, especially on cooked meats and seafood. If leftovers feel sticky or slimy to the touch, it’s best to toss them immediately. Additionally, any unusual change in firmness or a clumpy, stringy texture can signal that bacteria or mold are developing. Remember, even if the food looks okay visually or smells fine, these texture changes are often the first signs that harmful bacteria are present. When in doubt, discard leftovers with questionable textures to avoid food poisoning. Being aware of food safety guidelines can help prevent illness and ensure your leftovers are safe to enjoy. Understanding microbial growth patterns can further aid in recognizing spoilage signs before consumption. Recognizing these textures early can help prevent foodborne illnesses from developing.

Mold Test Kit for Home – 12 Simple Detection Tests,Test HVAC System,Home Surfaces,& Indoor Air Quality Testing Kits,DIY Mold Detector at Home,Includes Detailed Mold Identification Guide,air Tester
The Kayenqo Mold Test Kit contains 12 test plates, detailed mold guide and mold removal instructions, 12 swabs,…
As an affiliate, we earn on qualifying purchases.
As an affiliate, we earn on qualifying purchases.
Signs of Mold or Visible Growth on Food
If you notice unusual color changes on your food, it’s a warning sign you shouldn’t ignore. Visible mold growth or fuzzy spots are clear indicators that the food has gone bad and could cause illness. Additionally, a foul odor often accompanies these signs, so trust your senses before eating. Be aware that proper storage of leftovers can help prevent mold and spoilage. Proper storage techniques, such as sealing leftovers tightly and refrigerating promptly, can significantly reduce the risk of microbial growth and foodborne illness. Ensuring that leftovers are stored at the correct temperature can also help inhibit the development of harmful microorganisms that lead to spoilage. Staying informed about crypto pump patterns can help you recognize exchanges or foods that might be contaminated or unsafe. Using food safety guidelines can further minimize the chance of consuming contaminated food.
Unusual Color Changes
Have you ever noticed unusual colors or fuzzy spots on your food? These color anomalies or unusual hues can be a red flag that your leftovers are no longer safe. Bright, dull, or off-color patches often indicate spoilage or bacterial growth. If the food exhibits a strange tint or discoloration that wasn’t there before, it’s best to toss it. Additionally, food safety guidelines of food safety can help you identify signs of spoilage more accurately. Proper storage techniques, such as maintaining the correct temperature and avoiding cross-contamination, are also crucial in preventing safety hazards and foodborne illnesses. Recognizing visual cues like mold or abnormal coloration is a key step in preventing illness from spoiled leftovers. Being aware of storage practices can further reduce the risk of unseen spoilage developing over time.
Visible Mold Growth
Visible mold growth is a clear and alarming sign that your food has gone bad. Mold identification is essential, as it often appears as fuzzy or discolored spots, usually green, black, white, or blue. If you see any mold on leftovers, it’s safest to discard them immediately. Mold can penetrate beneath the surface, so even if it’s only visible on top, the entire food may be contaminated. Proper food safety practices include inspecting food carefully before storing or eating leftovers, and when in doubt, it’s better to toss them. Recognizing visible mold growth promptly helps prevent food poisoning and ensures you stay safe. Incorporating knowledge about auditory processing can also aid in understanding how sensory cues like smell or visual signs can alert you to food spoilage.
Foul Odor Presence
A foul odor emanating from your food is a strong warning sign of spoilage, often indicating mold growth or bacterial activity. If your leftovers smell off, it’s best to discard them immediately to prevent food poisoning. Pay attention to the smell, as it can often be more reliable than visual cues alone. Proper storage tips, like airtight containers and refrigeration at the right temperature, help slow bacterial growth and keep your food safe longer. Remember, even if food looks okay, a strong odor can mean it’s unsafe to eat. Always trust your nose—don’t risk eating spoiled leftovers. When in doubt, throw it out. Ensuring food safety is essential to avoid health issues caused by contaminated food. Additionally, investing in reliable home security systems can help protect your household from unexpected threats. Being aware of food spoilage indicators can further help you make safer choices about leftovers and reduce waste. Recognizing proper storage techniques can also extend the freshness of your leftovers and minimize the chances of spoilage. Implementing appropriate cleaning practices in your kitchen can further reduce the risk of contaminating stored food.

Servsafe Food Safety Manager's Certification Study Guide 2026 Includes Testing Tips and an Advanced Practice Test
The New 2024 Food Manager's Safety Guide. New current updated FDA food code. Great new study guide book…
As an affiliate, we earn on qualifying purchases.
As an affiliate, we earn on qualifying purchases.
How to Detect Off-Flavors or Sour Tastes in Leftovers

When you open leftovers, pay attention to any sour odors that seem out of place. If it smells off, don’t take a chance—trust your nose. You can also taste a tiny bit to check for unusual or off-flavors before deciding whether to eat it.
Recognizing Sour Odors
Ever wondered how to tell if leftovers have gone bad? Recognizing sour odors is key. When leftovers emit a sharp, vinegar-like smell, it’s often a sign of fermentation or bacterial activity. These sour odors indicate that bacteria are thriving, increasing the risk of food poisoning. Pay attention to these fermentation signs, as they warn you to toss the food immediately.
Here are some clues to look for:
- A strong, tangy smell that’s unfamiliar
- A pungent, sour aroma that dominates the dish
- Any change in smell compared to when you first stored it
- A noticeable off-putting scent that intensifies over time
Trust your nose—if it smells sour or off, it’s safest to discard the leftovers.
Tasting Off-Flavors
Detecting off-flavors in leftovers is essential because taste often reveals spoilage before smell or appearance do. During a quick taste test, you might notice a flavor change—sourness, bitterness, or metallic notes—that signals it’s time to toss. Off-flavors can develop even when food looks fine. Use your palate to identify these subtle signs; don’t ignore a strange or unusual taste. Here’s a visual guide:
| Off-Flavors to Watch For | What It Tells You |
|---|---|
| Sour or acidic taste | Bacterial activity, spoilage likely |
| Metallic or bitter | Chemical change, possible contamination |
| Unusual aftertaste | Food may be unsafe to eat |
Trust your taste buds—if the flavor change feels off, discard the leftovers.
Should You Toss Leftovers That Cause Stomach Upset or Food Poisoning Symptoms?

If your leftovers cause stomach upset or symptoms of food poisoning, it’s safest to discard them out rather than risk getting sick again. Consuming contaminated leftovers can worsen your condition or lead to more serious health issues. To prevent this, avoid reheating leftovers that caused symptoms in the first place. Instead, focus on proper leftover reheating tips to ensure safety. Remember, food poisoning prevention starts with vigilance.
- Don’t reheat leftovers that caused symptoms; discard them immediately
- Use a food thermometer to ensure leftovers reach 165°F during reheating
- Store leftovers promptly in airtight containers in the fridge
- Always check for off-odors or slimy textures before eating leftovers
When in doubt, it’s better to be safe than sorry to protect your health.
Best Practices for Storing Leftovers to Prevent Food Safety Risks

Proper storage of leftovers is essential to prevent bacterial growth and reduce the risk of foodborne illnesses. Follow food storage tips such as promptly refrigerating leftovers within two hours of cooking and using airtight containers to keep food fresh. Label leftovers with dates to track their freshness and avoid keeping them too long. When reheating, always follow reheating guidelines: heat leftovers to an internal temperature of 165°F (74°C) to kill bacteria. Store leftovers in small, shallow containers to assure even cooling and quick refrigeration. Avoid leaving leftovers in the danger zone (40°F–140°F) for too long. By practicing these food storage tips and reheating guidelines, you notably lower the chance of contamination and keep your food safe to enjoy later.
Frequently Asked Questions
How Long Can Leftovers Safely Stay in the Refrigerator?
You should generally consume leftovers within 3 to 4 days to stay safe. Follow proper storage guidelines by promptly refrigerating leftovers in airtight containers and setting your fridge to 40°F or below. Use refrigeration tips like labeling leftovers with dates, and avoid leaving food out at room temperature for more than two hours. If in doubt, trust your senses—when in doubt, toss it to prevent food poisoning.
What Are the Most Common Bacteria Causing Food Poisoning From Leftovers?
You should be aware that bacterial contamination from leftovers often involves foodborne bacteria like Salmonella, Campylobacter, and Listeria. These bacteria can grow rapidly if leftovers sit too long or aren’t stored properly, increasing your risk of food poisoning. To avoid illness, always reheat leftovers thoroughly, store them promptly, and discard any leftovers that have been in the fridge beyond safe time limits, typically 3-4 days.
Can Reheating Leftovers Eliminate All Foodborne Pathogens?
Reheating leftovers won’t wipe out all foodborne viruses and bacteria, and it might seem like a superpower, but it’s not. Proper reheating at the right temperature can kill most bacteria, but spoilage indicators like changed smell, texture, or color signal the presence of dangerous pathogens. Always check your leftovers for signs of spoilage and reheat thoroughly to reduce risks, but when in doubt, toss it out.
Are There Specific Leftovers That Are Safer to Discard Immediately?
Yes, you should immediately discard high-risk leftovers like cooked seafood, poultry, or dishes containing eggs if they’ve been left out for over two hours. Quick discard foods, such as cooked rice or pasta, can also harbor bacteria quickly. These foods are more prone to bacterial growth, so it’s safer to toss them right away to prevent food poisoning. When in doubt, it’s better to err on the side of caution.
How Do I Properly Label and Date Leftovers for Safety?
If you want to keep leftovers safe, think of your fridge as your own time machine. You should always use expiration labels and proper dating on containers to track freshness. Write the date you cooked or opened the leftovers clearly on the container with a permanent marker. This way, you’ll know exactly when to consume or toss them, reducing the risk of foodborne illness and keeping your kitchen safe and organized.
Conclusion
Knowing when leftovers have gone bad is your best defense against food poisoning. Trust your senses—odor, appearance, texture, and taste—like a detective on the trail. When in doubt, toss it out; don’t let spoiled food sneak past your defenses. Remember, leftovers are like ticking time bombs if not stored properly. Stay vigilant, keep safety your top priority, and your kitchen will be a fortress against unwanted guests—foodborne illnesses.